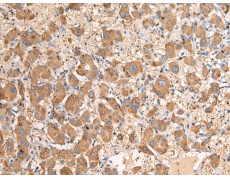
一抗

英文名稱: Anti-CES1 rabbit polyclonal antibody
別 名: carboxylesterase 1; CEH; REH; TGH; ACAT; CE-1; CES2; HMSE; SES1; HMSE1; PCE-1; hCE-1
相關(guān)類別: 一抗
儲(chǔ) 存: 冷凍(-20℃)
宿 主: Rabbit
反應(yīng)種屬: Human
標(biāo) 記 物: Unconjugate
克隆類型: rabbit polyclonal
技術(shù)規(guī)格
|
Background: |
This gene encodes a member of the carboxylesterase large family. The family members are responsible for the hydrolysis or transesterification of various xenobiotics, such as cocaine and heroin, and endogenous substrates with ester, thioester, or amide bonds. They may participate in fatty acyl and cholesterol ester metabolism, and may play a role in the blood-brain barrier system. This enzyme is the major liver enzyme and functions in liver drug clearance. Mutations of this gene cause carboxylesterase 1 deficiency. Three transcript variants encoding three different isoforms have been found for this gene. |
|
Applications: |
ELISA, IHC |
|
Name of antibody: |
CES1 |
|
Immunogen: |
Fusion protein of human CES1 |
|
Full name: |
carboxylesterase 1 |
|
Synonyms: |
CEH; REH; TGH; ACAT; CE-1; CES2; HMSE; SES1; HMSE1; PCE-1; hCE-1 |
|
SwissProt: |
P23141 |
|
ELISA Recommended dilution: |
5000-10000 |
|
IHC positive control: |
Human liver cancer |
|
IHC Recommend dilution: |
100-300 |


 購物車
購物車 幫助
幫助
 021-54845833/15800441009
021-54845833/15800441009